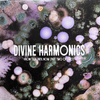

- PLAY ALL / Kuniyuki Takahashi / Joaquin Joe Claussell - a1 Kuniyuki Takahashi & Joaquin Joe Clausse - From Then Until Now (The Cosmic Arts Epic Version.mp3 (Divine Harmonics - From Then Until Now (Part Two Of Two) Plum Vinyl) / Kuniyuki Takahashi / Joaquin Joe Claussell - b1 Kuniyuki Takahashi & Joaquin Joe Clausse - From Then Until Now (The Cosmic Arts Epic Version) (Drum dub part 2).mp3 (Divine Harmonics - From Then Until Now (Part Two Of Two) Plum Vinyl)
- a1 Kuniyuki Takahashi & Joaquin Joe Clausse - From Then Until Now (The Cosmic Arts Epic Version.mp3 / Kuniyuki Takahashi / Joaquin Joe Claussell - a1 Kuniyuki Takahashi & Joaquin Joe Clausse - From Then Until Now (The Cosmic Arts Epic Version.mp3 (Divine Harmonics - From Then Until Now (Part Two Of Two) Plum Vinyl)
- b1 Kuniyuki Takahashi & Joaquin Joe Clausse - From Then Until Now (The Cosmic Arts Epic Version) (Drum dub part 2).mp3 / Kuniyuki Takahashi / Joaquin Joe Claussell - b1 Kuniyuki Takahashi & Joaquin Joe Clausse - From Then Until Now (The Cosmic Arts Epic Version) (Drum dub part 2).mp3 (Divine Harmonics - From Then Until Now (Part Two Of Two) Plum Vinyl)
Limited Plum Colored, Full colored Vinyl 12” Jacket 12 Inch Release
Hot on the heels of the recently released Divine Harmonics – From Then Until Now (Part One of Two) the limited orange vinyl edition that sold out within weeks, we are thrilled to announce the arrival of the highly anticipated Part Two of Kuniyuki and Joaquin “Joe” Claussell’s Divine Harmonics imprint.
This next installment is expected to surpass the excitement of both earlier releases, especially as it comes as a plum colored vinyl packaged in a stunning full-color jacket designed by the incomparable Akemi Shimada. As with all Divine Harmonics editions, this is a strictly limited full 12-inch package, created with collectors in mind.
Recorded in a fully equipped studio in Brooklyn, New York, this project was born from the idea of gathering musicians who deeply admire Kuniyuki’s work and inviting them to contribute to the composition.